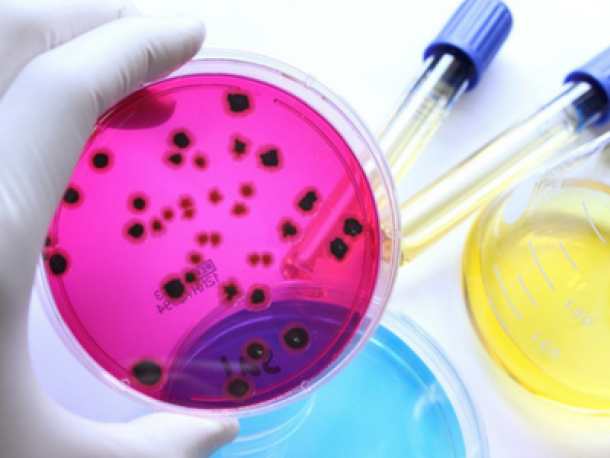
El bioburden de los productos sanitarios

Café “cold brew” y RTD: seguridad microbiológica, vida útil y validaciones para 2025
El auge del cold brew y de las bebidas listas para tomar (RTD) abrió oportunidades y también desafíos de inocuidad. A diferencia de un café caliente, el cold brew se extrae a temperatura ambiente o refrigerada y suele…
La Importancia de los Suelos en las Actividades Productivas
Los suelos del planeta son esenciales para el mantenimiento de la biósfera (la parte de la Tierra donde existe vida), así como para la regulación del…
¿Etiqueta libre de sellos o semáforo?
En la actualidad, en varios países existe la polémica decisión sobre el etiquetado que se debe utilizar en los alimentos. En el Perú, tras el mediáti…
Dificultades de los edulcorantes naturales para entrar al mercado industrial
Debido a la alta cantidad de casos que se suman año tras año causados por edulcorantes artificiales, la industria alimenticia y los consumidores han…
El bioburden de los productos sanitarios
El bioburden es un término que se utiliza para describir el número de microorganismos presentes en una superficie de un objeto, dentro de él o en una…
Retos ante la demanda mundial de nitrógeno para la producción de alimentos
El nitrógeno es un elemento que tiene un alto impacto sobre el medio ambiente, su importancia sobre los sistemas agrícolas y la producción de aliment…
Reglamentación de los materiales utilizados para envasado de alimentos
En las últimas décadas a nivel mundial ha venido cobrando gran importancia la industria de los envases en la inocuidad alimentaria. La Unión Europea…
¿Conoces los nuevos cambios de la FDA para el etiquetado nutricional?
Hace más de 20 años fue introducido al sector alimenticio de Estados Unidos la regulación de Etiquetado Nutricional, NLEA por como es conocida en sus…
EUROFINS IT... Un sueño hecho realidad
Han pasado 10 años desde la primera visita que realizamos a Dr. Specht en Alemania, el objetivo en aquel tiempo era traer una solución al sector expo…
Clorpirifos: ¿Cómo afectan a la salud? Disposiciones de LMR
El Clorpirifos es un insecticida (se utiliza para controlar las plagas de insectos) organofosforado cristalino que inhibe la acetilcolinesterasa caus…
Estudio de vida útil ¿Exigencia o necesidad empresarial?
La actual Ley de la Salud en Perú, establece que todo alimento y bebida elaborados industrialmente, de producción nacional o extranjera, sólo podrán…
¿Cuáles plagas debemos monitorear en nuestra higuera y cómo debemos hacerlo?
Las plagas se catalogan como las enfermedades en los cultivos, cualquier daño que un animal pueda causar al mismo y que ocasione perdidas para el agr…
Riesgos de migración de contaminantes desde el empaque al alimento
Más allá de las facilidades de almacenamiento y transporte que brindan los materiales de empaque para alimentos, su principal función radica en prote…